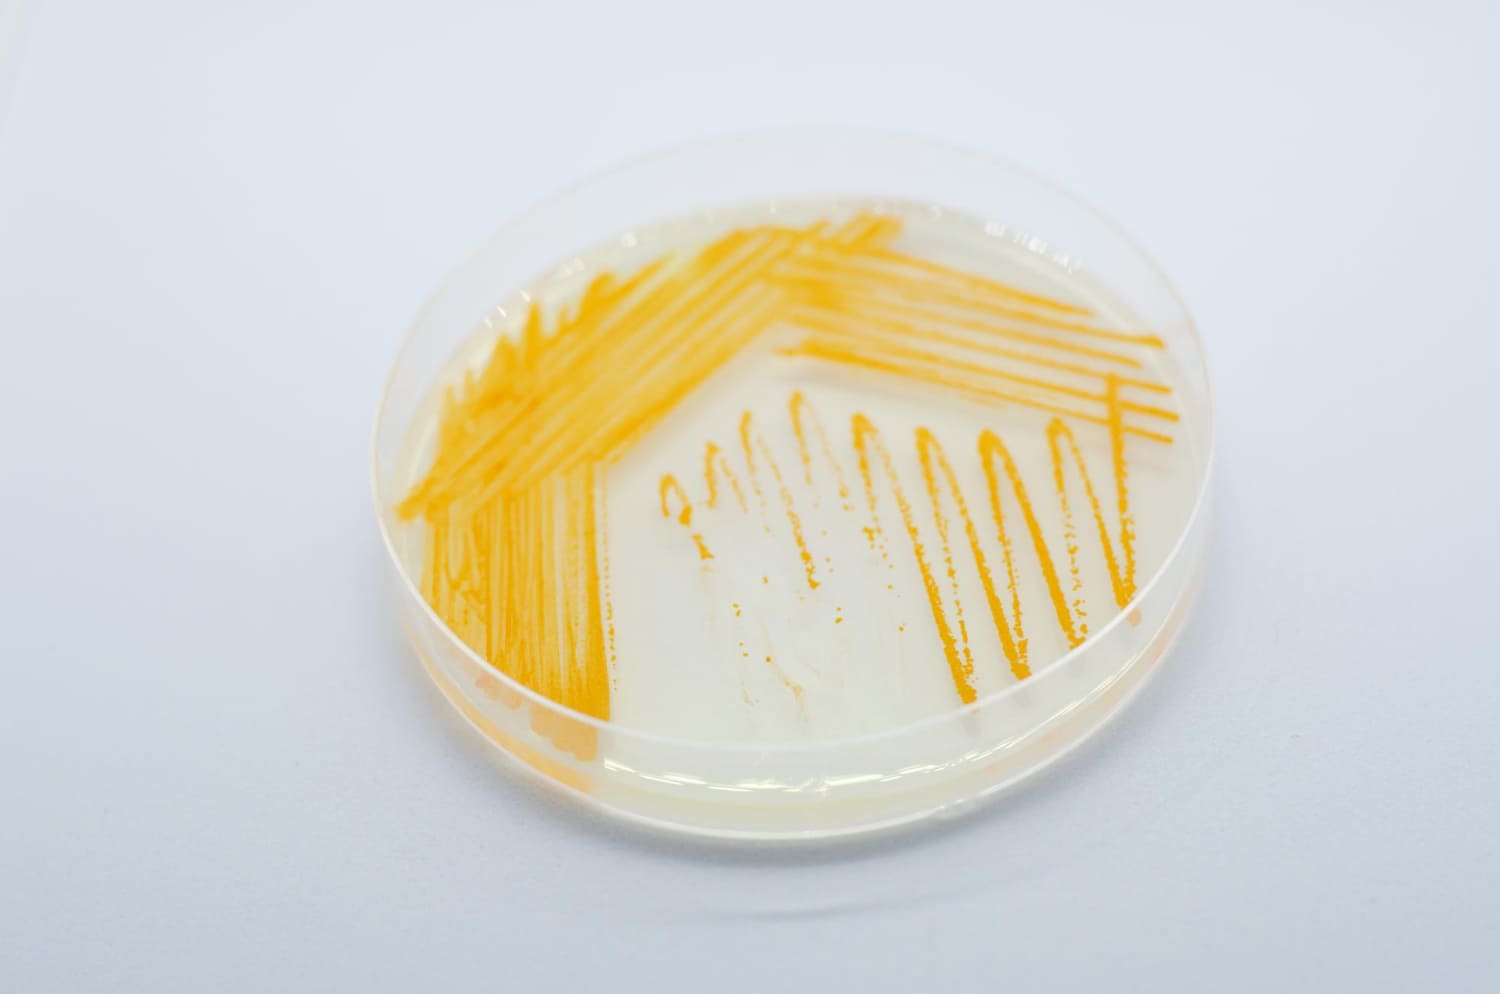
Urocultivo de Orina en una placa Petri

Prueba de análisis de Orina 24 horas
El análisis de orina de 24 horas es una de las pruebas médicas más solicitadas para evaluar la función renal, monitorizar distintas enfermedades y obtener datos sobre la cantidad de sustancias eliminadas por el organismo a lo largo de un día. Este examen permite determinar la excreción de componentes importantes como proteínas, electrolitos, creatinina y catecolaminas